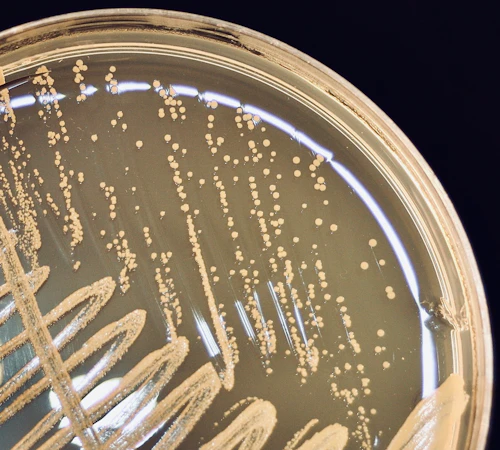

Biology Skills Certificate


A certificate recognizes that you have gone beyond the normal courseload in order to aquire specialized skills that are important in the labor market. We offer two types of skills certificates:
-STEM Skills Certificate
The Certificate of Competency in STEM is designed to enhance student preparation for diverse STEM careers, and the knowledge, skills, and abilities required to be successful. The Certificate emphasizes hands-on and applied experiences for specific technical competence, as well as skills aimed at broad preparation to enter a variety of STEM fields.
Required coursework to obtain a certificate in STEM Skills:
Bio 450
Bio 451
-Biotech Skills Certificate
Provides the student with skills and job training essential for the field of biotechnology. Jobs include technical positions in genetic engineering, forensics, bioinformatics, agriculture, pharmaceuticals, and medicine. This certificate program allows students to attain essential skills in biotechnology and provides opportunities to learn laboratory procedures and safety, how to record and analyze data, perform basic calculations and write laboratory documents. Students also learn about careers and ethical issues in biotechnology. Career Options: Careers for those with a Biotechnology Certificate of Achievement would include assay analyst, laboratory assistant or technician, manufacturing technician, QA/QC technician. Jobs for technicians may be found in environmental testing labs, forensic labs, hospitals, plant culturing labs, research labs and wineries.
Required coursework to obtain a Certificate in Biotech Skills:
CG 51 (College Success) or CG 54 (College Major and Career Exploration)
Bio 41T
Bio 42T
For more information about this certificate, please visit the Biotechnology Program website
-Biotech Certificate of Achievement
The Certificate of Achievement is similar to the Bio Skills Certificate, but it is geared for students wishing to transfer. In addition to the proficiency gained from the Skills Certificate, students will acquire a deeper set of skills that are useful toward their future B.S. degree.
Required coursework to obtain a Certificate in Biotech Skills:
Chem 1A
Bio 9A
Bio 41T
Chem 1B
Bio 42T
For more information about this certificate, please visit the Biotechnology Program website.